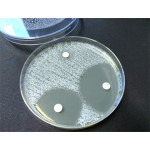
Test oxydase - 30 disques

Test oxydase - 30 disques
Oxidase Test Disc est un test de diagnostic utilisé pour la différenciation et l'identification microbienne, en particulier des bactéries Gram-négatives, sur la base de la présence de l'enzyme cytochrome oxydase.Le produit correspond aux recommandations de la norme EN ISO 16266 et ISO 9308-1 pour la détection de Pseudomonas aeruginosa et pour confirmation d'Escherichia coli et de bactéries coliformes, respectivement.
COMPOSITION
Chaque disque de disque d'essai d'oxydase est imprégné d'une solution de dichlorhydrate de N, N, N, N-tétraméthyl-p-phénylènediamine.![]()